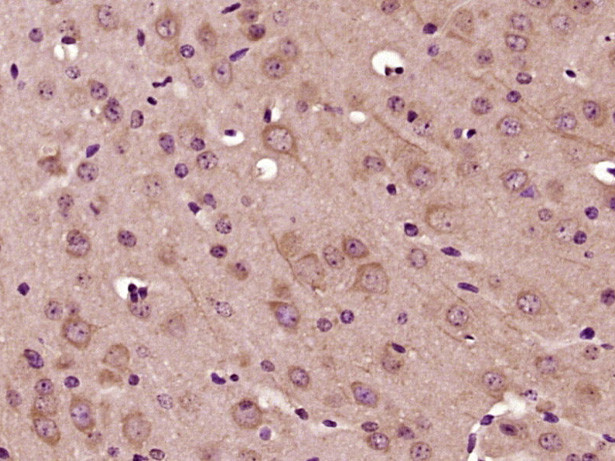
MADD Antibody in Immunohistochemistry (Paraffin) (IHC (P))

Search
Bioss
MADD Polyclonal Antibody
{{$productOrderCtrl.translations['antibody.pdp.commerceCard.promotion.promotions']}}
{{$productOrderCtrl.translations['antibody.pdp.commerceCard.promotion.viewpromo']}}
{{$productOrderCtrl.translations['antibody.pdp.commerceCard.promotion.promocode']}}: {{promo.promoCode}} {{promo.promoTitle}} {{promo.promoDescription}}. {{$productOrderCtrl.translations['antibody.pdp.commerceCard.promotion.learnmore']}}
图: 1 / 1
MADD Antibody (BS-14268R) in IHC (P)

产品信息
BS-14268R
种属反应
宿主/亚型
分类
类型
抗原
偶联物
形式
浓度
规格
纯化类型
保存液
内含物
保存条件
运输条件
靶标信息
Tumor necrosis factor receptor 1 (TNFR1) contains a death receptor domain that mediates interactions involved in downstream signaling of TNF. A novel protein, MADD (mitogen activated protein (MAP)-kinase activating death domain protein) has recently been shown to associate with the death domain of TNFR1 through its own C-terminal death domain. This interaction is critical for TNFR1 signal generation. Overexpression of MADD activates the MAP (Mitogen Activated Protein) kinases extracellular signal-related kinase (ERK) and c-Jun N-terminal kinase (JNK) and induces the phosphorylation of cytosolic phospholipase A2. This discovery suggests that MADD links tumor necrosis factor TNF and MAP kinase activation and arachidonic acid release. MADD has a 98% homology with another protein, differentially expressed in neoplasmic vs. normal cells (DENN). DENN is a substrate for JNK3, and is important in the hypoxia and stress induced intracellular signalling pathways. MADD also has a 93% sequence conservation with a GDP/GTP exchange protein, Rab3.
仅用于科研。不用于诊断过程。未经明确授权不得转售。
篇参考文献 (0)
生物信息学
蛋白别名: Differentially expressed in normal and neoplastic cells; IG20-SV4; signaling protein; Insulinoma glucagonoma clone 20; insulinoma-glucagonoma protein 20; Insuloma-Glucagonoma protein 20; KIAA0358; madd; MAP kinase-activating death domain protein; Rab3 GDP/GTP exchange factor; Rab3 GDP/GTP exchange protein; Rab3 GEP; Rab3GEP; RabGEF; RabGEP; signaling protein; unnamed protein product
基因别名: 9630059K23Rik; DEEAH; DENN; IG20; KIAA0358; MADD; NEDDISH; RAB3GEP; RabGEF
UniProt ID: (Human) Q8WXG6, (Mouse) Q80U28, (Rat) O08873
Entrez Gene ID: (Human) 8567, (Mouse) 228355, (Rat) 94193